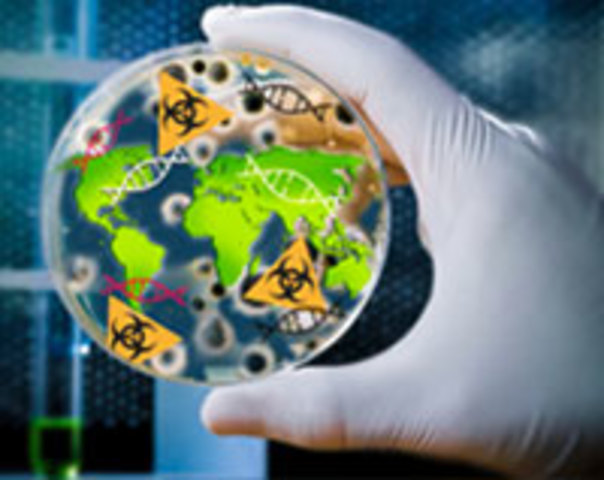
Protocolo de Cartagena sobre Seguridad de la Biotecnología,Cartagena, Colombia

-
Tal expresión se refiere al conjunto de relaciones entre el mundo natural y los seres vivientes, que influyen en la vida y el comportamiento del ser vivo.
-
Ámbito internacional
Disciplina jurídica que investiga, estudia y analiza las diferentes relaciones entre los bienes naturales y la actividad antrópica, orientando la regulación jurídica de las conductas y actitudes humanas respecto al uso, explotación y aprovechamiento de recursos naturales, conservación de la naturaleza y protección del ambiente. (Silvia Jaquenod). -
De las raíces griegas oikos y logos. Aparece en su obra Historia de la creación Natural. La designación se propuso al estudio de las relaciones de los seres vivos en una misma localidad, así como las adaptaciones en sus ambientes.
-
Paul Sarazin, encargado de la Liga Suiza para la Protección de la Naturaleza, convocó dicha conferencia, que más tarde se convertiría en la Unión Internacional para la Conservación de la Naturaleza y de sus Recursos.
-
El eólogo vegetal Sir George Tansley dice este concepto para explicar que cada hábitat es un todo integrado. Unidad de interacción de los organismos vivos entre si y de estos con el ambiente en un espacio y tiempo determinados.
-
Publicada en el Diario Oficial de la Federación, destaca las disposiciones específicas en materia de conservación de recursos naturales. México
-
Con base al artículo 27 de la Constitución de 1917, incorpora el concepto de conservación de los recursos naturales. La legislación ecología y ambiental del país tiene como origen los principios del art.27. México
-
Publicación de los estudios de Osborn sobre las consecuencias catastróficas que ocasionará la irregularidad de los recursos naturales.
-
Epidemia: envenenamiento del sistema nervioso central provocado por mercurio orgánico, encontrado en las cloacas de una fábrica química de la empresa Chisso.
-
El convenio trató la prevención de la contaminación del mar por hidrocarburos.
-
Sobre el impacto cada vez mayor de la actividad humana sobre la naturaleza y sus elementos.
-
La palabra ecología está presenta dentro del vocabulario general.
-
Estilo cercano a la ciencia ficción para analizar las consecuencias de los pesticidas según las recomendaciones del Departamento de Agricultura de Estados Unidos (USDA). Habla de la desaparición total de aves (pájaros) y un profundo desequilibrio en la naturaleza. Con él se logró La prohibición del DDT en la legislación estadounidense.
-
Estudios para atender los problemas derivados de la utilización de la energía nuclear. Este tratado prohíbe los ensayos nucleares en la atmósfera.
-
Se logró que el gobierno estadounidense obligara a la empresa General Motors a realizar algunas transformaciones técnicas al modelo del coche Corvair, por ser excesivamente inseguro.
-
Inicios del movimiento ecologista en Estados Unidos. Se dejó sin electricidad a gran parte de la costa este y sur de Canadá.
-
Hundimiento del buque petrolero Torrey Canyon que chocó contra los arrecifes de Seven Stones en el archipiélago de las Scilly frente a las costas de Gran Bretaña. Provocando una inmensa marea negra. Catástrofe ecológica que llamaron la atención mundial
-
Inicio del movimiento contra el uso de energía nuclear por los países industrializados como nueva fuente de energía.
-
Los movimientos ecologistas surgieron en el mundo desarrollado con las marchas de protesta. La Universidad de Berkeley fue cuna del primer grupo ecologista.
-
Análisis de los graves problemas originados por la explosión demográfica. También impulsó el movimiento Crecimiento demográfico cero, que promovió Técnicas de control natal y de esterilización
-
Creada por la Asamblea General de la ONU durante la presidencia de la Primera Ministra noruega Gro Harlem Brundtland
-
Primer informe que surgió de la comunidad científica para alertar sobre la limitación de los recursos y la explosión demográfica.
-
Fundada por David Browner. Fue una de las primeras organizaciones ecologistas a nivel mundial que dio pie para que funcionaran en Estados Unidos más de 3000 organizaciones ecologistas un año más tarde.
-
Adoptar reglas y procedimientos uniformes para dirimir toda cuestión de responsabilidad civil derivada de daños causados por la contaminación de aguas de mar por hidrocarburos. Aprobado en México en 1993.
-
Los matrimonios Bohlen y Stowe trataron de impedir la explosión nuclear estadounidense en Amchita, Alaska, prevista para 1971. Se fundó la organización No hagas olas.
-
Millones de personas participaron en el “Earth Day”. La conciencia ambientalista de la sociedad americana comprometió a su gobierno para que fundara la Environmental Protection Agency, mejor conocida como EPA.
-
Fue el fundamento para los primeros reglamentos relativos al control y prevención de la contaminación. Mexico
-
Centenares de personas manifestaron su desacuerdo por la construcción de la central nuclear de Fessenheim, Alsacia, originando un gran movimiento antinuclear francés.
-
Poco más de 200 científicos del mundo enviaron a la ONU el Mensaje Menton en el que alertaban la degradación del medio ambiente.
-
Primera reforma que se puede definir como ecológica, la que incorpora el principio de prevención y control de la contaminación. México
-
Los matrimonios Bohlen y Stowe llevan a cabo su protesta utilizando el barco llamado Greenpeace, del cual surgió el nombre y el enfoque de esa conocida organización ecologista.
-
Se funda en Tasmania, Australia, el primer partido ecologista: “United Tasmania Group”, designado después Values Party, en Nueva Zelanda.
-
Acerca de los límites de crecimiento.
-
Primera Conferencia de las Naciones Unidas sobre el Medio Ambiente y el Desarrollo. La cual generó una serie de principios independientes, manifestados en la Declaración de Estocolmo y la creación del Programa de las Naciones Unidas para el Medio Ambiente. (PNUMA)
-
Numerosas personas se opusieron a la ampliación de la base militar de Larzac, en Francia. Esa manifestación fue el punto de referencia que reunió al movimiento ecologista y pacifista francés.
-
Regular de manera estricta el comercio de especímenes de flora y fauna silvestres, a fin de no poner en peligro su supervivencia. México se adhirió 18 años después en junio de 1991.
-
Como respuesta a los problemas de salud por contaminación ambiental atmosférica se creó la subsecretaría para el mejoramiento del medio ambiente.
-
Cientos de activistas antinucleares invadieron los terrenos donde se pretendía construir la central nuclear de Whyl, cercana a la ciudad de Friburgo. El tribunal paralizó las obras el 21 de marzo y el 14 de mayo se descartó la construcción de dicha central. Iniciando el movimiento antinuclear alemán.
-
Primer accidente grave conocido en una central nuclear. A partir de ese año, el movimiento ecologista antinuclear se fortaleció al lograr paralizar los programas nucleares en varios países industrializados.
-
Una espesa nube de dioxinas contaminó la zona de Seveso, en Italia, la cual intoxicó a muchas personas y obligó a desalojar una amplia zona del norte de Milán.
-
Se celebra el congreso de Mujeres sobre el Medio Ambiente, en el cual el feminismo se acercó a los problemas ecológicos.
-
A medida que la humanidad ha llegado a estar consciente de los abusos y limitaciones del medio ambiente, los alcances del pensamiento de la gente y el tema que trata la ecología se han extendido. La Ecología integra ciencias físicas, biológicas y sociales.
-
Controlar y restringir la emisión de compuestos orgánicos volátiles con el fin de reducir los flujos transfronterizos de estos componentes como de los productos oxidantes fotoquímicos secundarios que resulten de ellos, protegiendo de ese modo la salud y el medio ambiente de sus efectos nocivos.
-
Científicos anuncian que cada primavera, desde 1970, sobre la Antártida, se observa un agujero en la capa de ozono el cual es causado por los gases Clorofluorocarbonados (CFC’s).
-
Tuvo por objeto establecer las normas para la conservación, protección y restauración del medio ambiente, de los recursos que lo integran, y para la prevención y control sobre los contaminantes y causas que los originan. México
-
Se crea la secretaría de desarrollo urbano y ecología, para formular e impulsar la política ecológica
-
Aparece la materia ecológica en el artículo 26, causado por ser los principales reclamos de la población. México
-
Este se enfoca únicamente en la contaminación, con un carácter estrictamente federal en cual se aplican multas, sanciones y denuncias.
-
Establece en el párrafo sexto las modalidades y las actividades de control y prevención de la contaminación industrial. México
-
Incluye el derecho a la salud, como parte integrante del listado de garantías individuales. México
-
Se adiciono y reformo con el fin de dar una transformación al régimen municipal, incluye el concepto de zona de reserva ecología como un área de jurisdicción municipal. México
-
El PNUMA alertó acerca de los procesos de desertización ocasionados por la acción humana.
-
Se efectuó una fuga de gas tóxico en la empresa Unión Carbide que provocó la muerte inmediata de 2 000 personas y lesionó a otras 200 000. Se puso en evidencia las crecientes dificultades que originan las actividades industriales de alto riesgo en los países industrializados y la estrategia de las compañías transnacionales de trasladarse a países del tercer mundo, los cuales son menos estrictos en sus leyes y controles respecto a dichas actividades
-
Su objetivo es proteger la salud humana y el medio ambiente contra los efectos adversos resultantes o que puedan resultar de las actividades humanas que modifiquen o puedan modificar la capa de Ozono. México es parte de este tratado internacional.
-
El cuarto reactor nuclear de la central de Chernobyl estalló debido a que se fundió el núcleo del reactor, lo que obligó evacuar a 140 000 personas. En 1990 se atendió y controló a poco más de 600 000 personas afectadas por las emisiones radiactivas a las que estuvieron sometidas.
-
Se establecen las facultades de la Asamblea de Representantes, y una de estas es que tengan por objeto atender las necesidades que se manifiesten entre los habitantes en materia ecológica. México
-
La comisión Mundial sobre el Medio Ambiente y el Desarrollo propone adoptar un programa a nivel mundial para lograr un desarrollo sostenible. Se emplea por primera vez el término Desarrollo sustentable, como una evolución que permita satisfacer las necesidades de la generación actual sin perjudicar las de las futuras generaciones.
-
Incluye no solo el aspecto de conservación, si no que se prevé la posibilidad de preservar y restaurar el equilibrio ecológico del país. México
-
Establece un sistema de concurrencias en la materia de protección al ambiente y de preservación y restauración del equilibrio ecológico. México
-
Su finalidad es eliminar las sutancias que pueden agotar considerablemente la capa de ozono y modificarla de alguna otra manera, con posibles efectos nocivos en la salud y en el medio ambiente. Adoptado también por México.
-
Se crea la LGEEPA, máxima ley del derecho ambiental en México que regula lo relativo al cuarto párrafo del artículo 4 de la Constitución Política.
-
Aparece la materia ecológica en el artículo 26, causado por ser los principales reclamos de la población. México
-
La NASA presentó pruebas sobre las primeras consecuencias del efecto invernadero.
-
Los aspectos que abarca esta ley son: Contaminación Lumínica, Contaminación radioeléctrica, Contaminación atmosférica, Rutas aéreas.
-
Iniciativa para implementación de leyes y reglamentos en el Estado de Baja California contra la CONTAMINACIÓN LUMÍNICA con el propósito de preservar y cuidar el cielo oscuro en paisajes culturales urbanos, parques nacionales y sitios relacionados con las observaciones astronómicas, así como apoyar los objetivos de la UNESCO en su iniciativa de Astronomía y Herencia Mundial
-
Señala que la materia ambiental es prioritaria. México
-
Tiene una orientación abocada a la búsqueda del desarrollo sustentable.
-
Su objeto principal es reducir al mínimo la generación de desechos peligrosos desde el punto de vista de la cantidad y de los peligros potenciales, para proteger la salud humana y el medio ambiente de los daños que entrañan tales desechos. Así como de controlar, los desechos transfronterizos de esos desperdicios. México forma parte de este tratado.
-
Tienen como objetivo primario la protección de cuencas hidrográficas para asegurar el abastecimiento de agua a las poblaciones, requiriendo de declaración presidencial para su formación.
-
Se confirmó la presencia de otro agujero sobre el Polo Norte.
-
Su finalidad es la protección del medio ambiente antártico y los ecosistemas dependientes y asociados, así como designar a la Antártida como reserva natural consagrada a la paz y a la ciencia.
-
Teoría económica de Aimeé Figueroa. El avance más significativo económico fue que el medio ambiente adquiera la categoría de capital. “… no es sólo la tierra la que crea valor, sino la naturaleza y el medio ambiente global”.
-
Surge a partir del requisito de ocuparse y contrarrestar el desgaste al medio ambiente en México. Enfocándose no solo en las ciudades sino también a las diferentes regiones naturales con la que cuenta el país, como lo son sus costas, desiertos, selvas y bosques.
-
Surgió al reconocer que las actividades humanas han incrementado de manera sustancial las concentraciones de gases de efecto invernadero en la atmósfera, lo que ocasionará un calentamiento adicional a la superficie y la atmósfera terrestres, afectando negativamente a los ecosistemas naturales como a la humanidad
-
Se llevó a cabo la Conferencia de las Naciones Unidas sobre el Medio Ambiente y el Desarrollo, a la cual asistieron jefes de Estado de varios países, simbolizando la preocupación de la opinión pública sobre el deterioro del medio ambiente.
-
Firmado por 163 Estados. Dejó plasmada la preocupación internacional debido a la considerable reducción de la biodiversidad en el orbe como consecuencia de las actividades humanas. Se comprometen, los países a conservar y a utilizar de manera sostenible su riqueza natural de flora y fauna.
-
Es un órgano centralizado de la administración pública federal encargado de ofrecer programas y apoyos al pueblo, a través de la administración de recursos para el mismo propósito; además de crear programas para combatir la pobreza
-
Dentro del Convención Marco sobre el Cambio Climático. Contiene los compromisos asumidos por los países industrializados de redcir sus emisiones de algunos gases de efecto invernadero, responsables del calentamiento global: Dióxido de Carbono, Metano, Óxido Nitroso, Hidrofluorocarbonos, Perflurocarbonos, Hexafluoruro de azufre.
-
Surge la necesidad de articular en una sola institución, que fuera la responsable de formular y vigilar el cumplimiento de leyes y normas en materia ambiental; así como para inducir el aprovechamiento en materia racional de los recursos naturales renovables, no solo por su preservación, sino para asegurar la base natural del desarrollo económico nacional y mejorar el nivel de vida de la población garantizando su sustentabilidad presente y futura.
-
Señala que la materia ambiental es prioritaria. México
-
Su objetivo es asegurar la conservación a largo plazo y el usos sustentable de las poblaciones de peces transzonales y altamente migratorias, mediante la aplicación efectiva de las disposiciones reguladas en dicho acuerdo internacional.
-
Resultado de atender a uno de los mandatos del Convenio sobre la diversidad Biológica. Garantizar un nivel adecuado de protección en la esfera de transferencia, manipulación y utilización seguras de los organismos vivos modificados resultantes de la biotecnología moderna que puedan tener efectos adversos para la conservación y la utilización sustentable de la diversidad biológica, y centrándose concretamente en los movimientos transfronterizos.
-
El medio ambiente se hace derecho humano desde la perspectiva de esta época.
-
Los países participantes aceptaron que no se han alcanzado los objetivos fijados en la Cumbre de la Tierra y que el avance hacia un desarrollo sustentable es más lento de lo previsto. Se destaca la creciente pobreza en el mundo. Se fijaron compromisos y acciones a realizar en dos documentos básicos: “El Compromiso de Johannesburgo por un Desarrollo Sostenible” y un plan de aplicación de las decisiones de la Cumbre Mundial sobre el Desarrollo sostenible.
-
Siguiendo los antecedentes de grandes observatorios localizados en Arizona, Hawái y en las Islas Canarias, se promulgó dicho Reglamento en Ensenada, para reducir el aumento de la contaminación lumínica.
-
-
-
Dentro de los objetivos está asegurar un renovado acuerdo político en desarrollo sustentable, evaluar los progresos y brechas en la implementación de los acuerdos ya realizados. Abordar los retos nuevos y emergentes. No se contó con la asistencia de Barack Obama y destacaron las manifestaciones en Irán en contra del presidente iraní como mal ejemplo en problemas ambientales
-
Los cambios que el ser humano ha ocasionado al ambiente en los últimos años al punto de poner en peligro la vida en la tierra, han tenido como consecuencia una transformación en la idea que había de la ética, ahora ligada con aspectos ambientalistas.
-
Habla de lo concerniente a áreas naturales protegidas y el aprovechamiento racional de los recursos naturales y sobre la “Protección del ambiente“, todo lo relativo a la contaminación. México
-
La creación de esta para prevenir y controlar la contaminación; reafirmándose con la preocupación mundial por la conservación ambiental expuesta en la convención de Estocolmo Suecia en 1972.
A list shows items. A timeline shows sequence.
Use Timetoast to make dates, milestones, and turning points easier to understand in a clear visual format. Timetoast is a timeline maker for work, school, research, and stories.